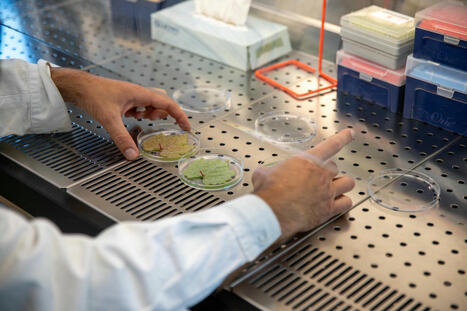
L'IA au service des vignes | Le fil d'actualit&eacute;s de l'URCA | Scoop.it

Your new post is loading...
 Your new post is loading...
"Philippe Jeandet, professeur salué internationalement pour ses contributions majeures dans le domaine de la biologie, de la biochimie, de la phytopathologie, de la vigne et du vin, nous a quitté il y a plus d’un an maintenant. La communauté universitaire de Reims Champagne-Ardenne et international rend hommage, à ce grand scientifique, à travers un éditorial dans le journal scientifique Biotechnologia."
"Le cycle des Rendez-vous de Bacchus reprendra le mardi 7 octobre 2025 à Reims. Ce rendez-vous mensuel, devenu incontournable pour les passionnés de vigne et de vin, réunit chercheurs, étudiants et amateurs autour de l’actualité vitivinicole."
"Qui sont les vignerons et vigneronnes de Champagne aujourd’hui ? Comment devient-on vigneron ? Comment le reste-t-on ? Que révèlent leurs parcours sur les évolutions profondes de la filière ? Ces questions sont au cœur du travail d’Océane Carneiro. Elle est doctorante en sociologie à l’Université de Reims Champagne-Ardenne. Ses recherches sont dirigées par les..."
"Depuis février 2025, l'Institut Georges Chappaz de la Vigne et du Vin en Champagne propose la formation "Champagne Spécialiste" au sein de la Villa Bissinger située a Aÿ-Champagne..."
"Invité par la Société historique de Bar-sur-Aube et du pays Baralbin, le Centre de recherche sur le commerce international médiéval tiendra sa journée d’étude annuelle vendredi à la Maison des arts sur la thématique du vin."
"Nouveau rebondissement dans la saga judiciaire opposant le château Petrus à la marque "Petrus Lambertini" : le tribunal de Bordeaux donne raison au premier en condamnant pour contrefaçon le négoce à l’origine de la seconde, qui prévoit de faire appel. Ce qui suspendrait le jugement..."

|
Scooped by
Université de Reims Champagne-Ardenne
December 18, 2023 4:52 AM
|
"Structure originale, mêlant coopératives et maisons de négoce, le groupe Terroirs & Vignerons de Champagne a mis les femmes au centre de ses instances dirigeantes."
"Lauréat du Prix Georges Chappaz en 2022, Mathieu Feneuil, qui a suivi un master relations internationales guerres et conflits (RIGC) à l’université de Lille, a présenté ses travaux mercredi 29 décembre à la Villa Douce de Reims."
"Voici une jurisprudence qui fait peser un risque d’illégalité sur des noms de sociétés dans tout le vignoble. Adoptant une stratégie de protection renforcée, à la champenoise, les vins AOC Côtes du Rhône obtiennent l’interdiction de la marque d’un négociant, qui estime servir de "bouc émissaire". D’autres dossiers sont en instruction rétorque le syndicat AOC."
"À l’occasion d’une nouvelle conférence sur l’histoire du champagne et de la Champagne, le musée d’Épernay recevra Benoît Musset, maître de conférences en histoire moderne à l’université du Mans, spécialiste des vignobles..."
"Sophie Quillet a pris en mars la tête de l’Institut Georges Chappaz de la vigne et du vin en Champagne, rattaché à l’Université de Reims Champagne-Ardenne."
Pour densifier et de développer les formations en matière de droit du vin et des spiritueux, l’Organisation internationale de la vigne et du vin (OIV), l’Association universitaire internationale de la vigne et du vi
"J’ai évoqué le lancement de l’étude il y a quelques mois (lire ici), en voici désormais les premiers résultats. Des résultats qui ont été dévoilés lors de l’assemblée générale de la commission des viticultrices du Syndicat général des vignerons de la Champagne présidée par Séverine Couvreur, nouvelle présidente (qui remplace Sophie Signolle)."
|
"Ce vendredi 10 octobre 2025, la manifestation « Sciences ça pousse » revient pour une deuxième édition à Chigny-les-Roses. L’occasion de parler des pathologies de la vigne, dont la flavescence dorée, et de discuter de ces thématiques avec des chercheurs et des viticulteurs."
"La science se penche sur les bienfaits cachés de la vigne. Des molécules extraites des sarments intéressent les laboratoires cosmétiques. Découverte des travaux menés à l'Université de Reims avec Émilie Thiébault."
"Le négociant à Cognac et ses partenaires publics et privés financent des recherches universitaires prometteuses. Il accueillait cette semaine en Charente les meilleurs spécialistes de la question."
"Des chercheurs ont abordé les sciences et techniques dans un lieu insolite au milieu des vignes."
"Depuis une dizaine d’années, trois unités de recherche de l'Université de Reims Champagne-Ardenne (URCA), en collaboration avec des acteurs renommés du..."
"La terre entière veut du bourgogne, peut-être est-ce simplement une mode. Alors qu’elle passe, que l’on puisse de nouveau en acheter… et en boire."
"Deux nouveaux règlements viennent renforcer la protection des indications géographiques face aux noms de domaine contrefaisants."

|
Scooped by
Université de Reims Champagne-Ardenne
November 16, 2023 3:42 AM
|
"Revirement de jurisprudence pour l’Office de l'Union Européenne pour la Propriété Intellectuelle qui valide une marque d'outils de cuisine ayant la même prononciation anglosaxonne que le champagne."
"Champagne. La première édition du « Sparkling Wine Forum », l'événement professionnel dédié à l'innovation dans la filière des vins effervescents, se déroulera le mardi 20 juin au Village by CA de Reims-Bezannes."
"De nouvelles formes de cuves apparaissent depuis quelques années et la cuve à vin en forme d’œuf est une de ses nouvelles formes."
"Lundi 27 mars 2023, Michel Bourqui, Délégué général de l’Association universitaire internationale de la vigne et du vin et Guillaume Gellé, président de..."
"La maison de champagne Krug a reçu cette signature de convention qui inscrit l’Université de Reims dans une démarche toujours plus pertinente en matière de formation, dans les domaines de la vigne et du vin."
|




 Your new post is loading...
Your new post is loading...